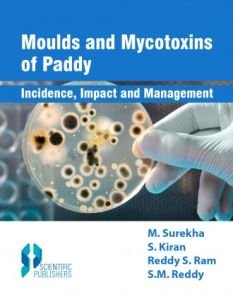

-
-
-
-
-
Nanoparticles Applications in Agriculture
Scientific Publishers, 2022, 180 p, ISBN: 9789391418229
$70.00 -
Nanomaterials: Synthesis, Properties and Applications
I.K International Publishing House, 2021, Pbk, 392 p, ISBN: 9789390620036
$35.00 -
-
-
-
Name Reactions : A Collection of Detailed Reaction Mechanisms
Springer, 2007, Third Expanded Edition, xx, 652 p, ISBN: 8181286758
$70.00 -
-
-
Multiple Choice Questions in Computer Science
I.K. International, 2011, pbk, First Reprint, 366 p, ISBN: 9788190675772
$22.00 -
-
Multicriterion Analysis In Engineering And Management
PHI Learning, 2010, pbk, 288 p, ISBN: 9788120339767
$22.00 -
Multi-Carrier Digital Communications : Theory and Applications of OFDM
Springer, 2008, pbk, Second Edition, xxii, 412 p, tables, figs, ISBN: 8181288912
$44.00 -
Moulds and Mycotoxins of Paddy : Incidence, Impact and Management
Scientific Publisher, 2018, 250 p, ISBN: 9789387307094
$85.00 -
-
-
-
Molecular Markers and Plant Biotechnology
New India Pub, 2010, xlviii, 578 p, 40 col. plates, figs, tables, ISBN: 9789380235257
$160.00 -
-
-
-
-
Molecular Biotechnology : Principles and Practices
Universities Press, 2006, pbk, x, 1218 p, tables, figs, ISBN: 9788173715013
$70.00 -
-
Molecular Biology: Principles and Techniques
Agrobios (India), 2022, 332 p, ISBN: 9789394380172
$90.00 -
Molecular Biology and Recombinant DNA Technology : Practical Manual Series Vol. II
Narendra Publishing House, 2011, x, 322 p, ISBN: 9380428321
$45.00 -
Molecular Biology and Biotechnology: Basic Experimental Protocols
Teri Books, 2013, pbk, 372 p, tables, figs, ISBN: 9788179933794
$40.00 -
Molecular Biology and Biotechnology : Microbial Methods
New India, 2010, xx, 360 p, tables, ISBN: 9789380235196
$95.00 -
Molecular Biology and Biotechnology
Nidhi Pub, 2008, Reprint, viii, 408 p, tables, figs, ISBN: 818915303X
$36.00